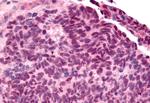
TLX Antibody in Immunohistochemistry (Paraffin) (IHC (P))

Search
Invitrogen
TLX Polyclonal Antibody
{{$productOrderCtrl.translations['antibody.pdp.commerceCard.promotion.promotions']}}
{{$productOrderCtrl.translations['antibody.pdp.commerceCard.promotion.viewpromo']}}
{{$productOrderCtrl.translations['antibody.pdp.commerceCard.promotion.promocode']}}: {{promo.promoCode}} {{promo.promoTitle}} {{promo.promoDescription}}. {{$productOrderCtrl.translations['antibody.pdp.commerceCard.promotion.learnmore']}}
产品信息
PA5-34003
种属反应
宿主/亚型
分类
类型
抗原
偶联物
形式
浓度
规格
纯化类型
保存液
内含物
保存条件
运输条件
RRID
靶标信息
Nuclear receptor TLX, a NR2 hepatocyte NF4-like receptor, has been shown to affect anterior brain differentiation, retinal development, and vision. It has been suggested that TLX targets genes for RAR beta2 and Pax2 during retinal development. Homozygous TLX mutant mice are viable at birth but exhibit reduced forebrain development and are more aggressive than wild-type mice. Mice with deleted TLX locus exhibit cerebral hypoplasia, blindness, and extreme aggression (fierce (frc) phenotype). TLX expression has been documented in mouse brain and eye. ESTs have been isolated from normal human brain libraries.
仅用于科研。不用于诊断过程。未经明确授权不得转售。
篇参考文献 (0)
生物信息学
蛋白别名: HTll; NR2E1; Nuclear receptor subfamily 2 group E member 1; Nuclear receptor TLX; Protein tailless homolog; similar to Drosophila tailless; tailes-related receptor; tailless; Tll; TLX; unnamed protein product
基因别名: NR2E1; TLL; TLX; XTLL
UniProt ID: (Human) Q9Y466
Entrez Gene ID: (Pig) 100155153, (Dog) 475017, (Horse) 100072159, (Rabbit) 100328698, (Human) 7101, (Bovine) 528156